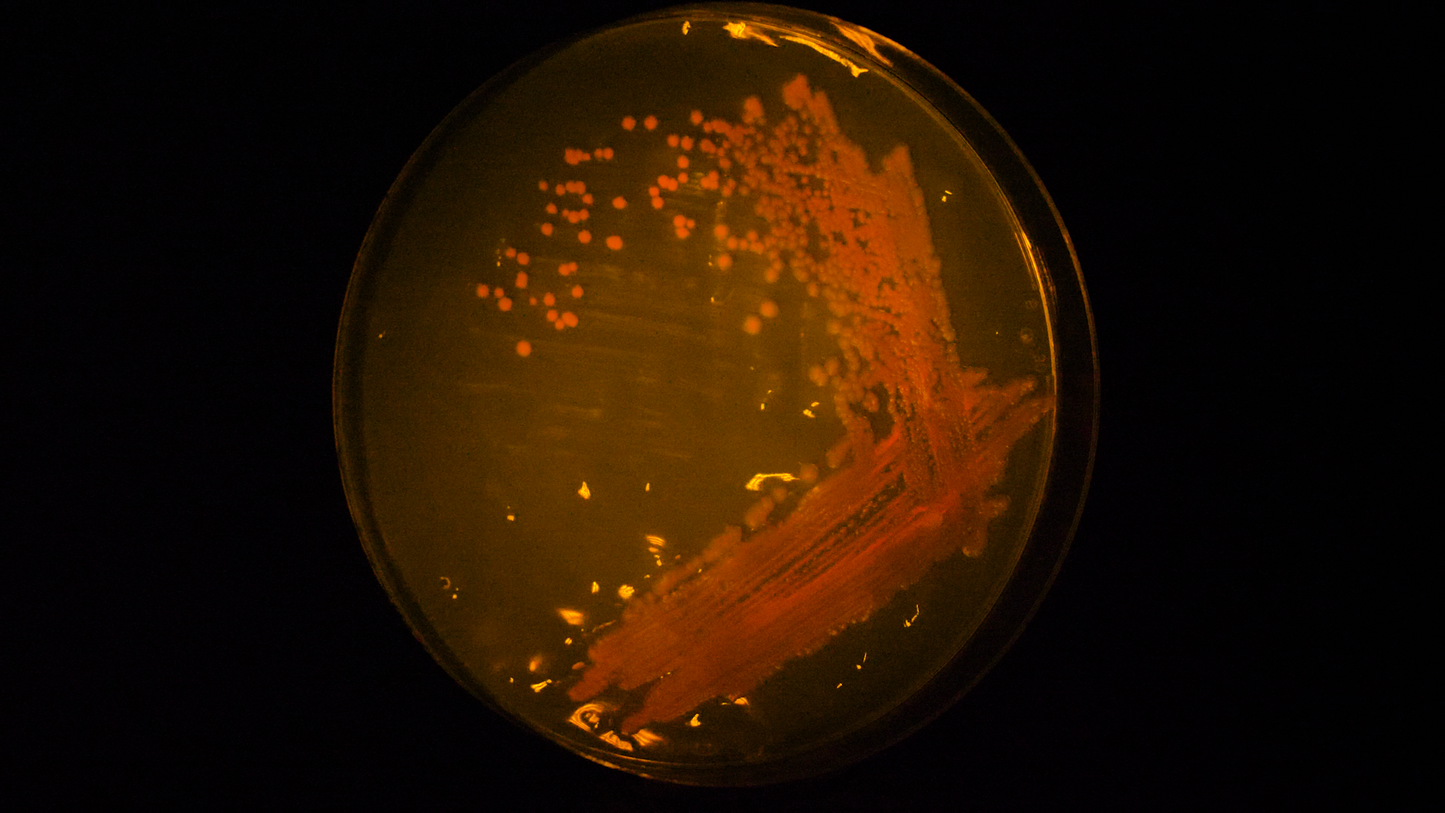
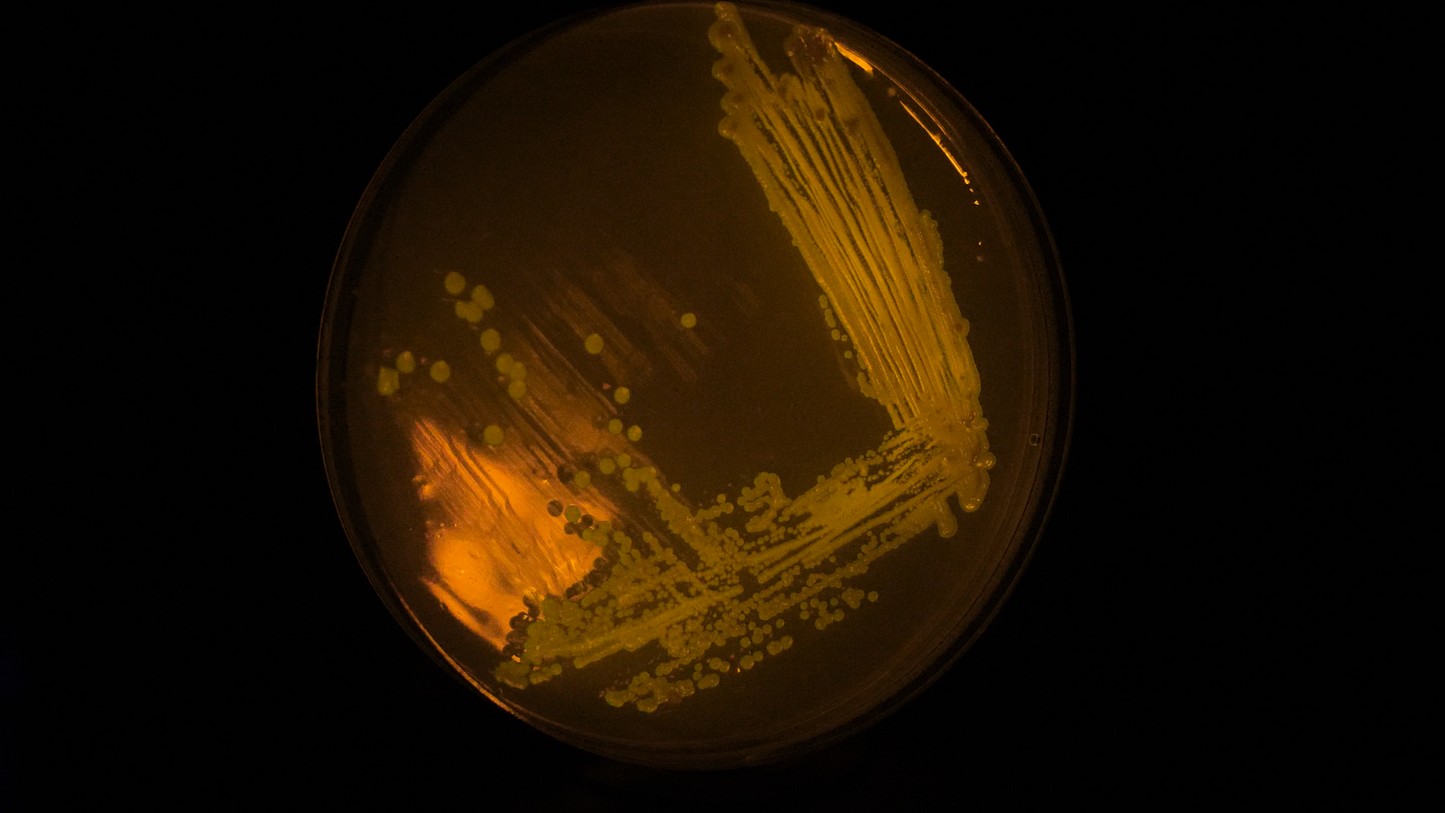

The Thought Emporium
Bistable Switch | Plasmid
Bistable Switch | Plasmid
Couldn't load pickup availability
This plasmid is an implementation of a simple transistor circuit. There are two sections of the plasmid, the transistor part, and the reporter part. The transistor part is composed of the lac and tet repressors wired to control each other. The reporter part consists of 2 fluorescent proteins to indicate what state the system is in.
When the plasmid is initially transformed into your E. coli strain of choice, it will settle randomly into one of the two states: red, and green. When streaked out onto plates containing lactose or IPTG, the switch will engage, and lock into the red state. This state should be maintained for the most part even if the bacteria are streaked out back on regular antibiotic plates.
However if the bacteria are streaked onto plates containing anhydrotetracycline (chosen for it’s ability to trigger the tet repressor without having antibiotic activity), the system will switch into a green/yellow state. Again this state should be stable until lactose is given.
The plasmid is based on pet9a, and as such uses kanamycin as the resistance marker, and is low copy. The DNA is provided as 10ug of freeze dried DNA and must be shipped express. Freeze and store at -20C on receipt.
Plasmid maps can be found on our github: HERE
These constructs are provided as open source for you to modify and use as you please. Though we do ask for attribution, and no direct commercial resale.
Share